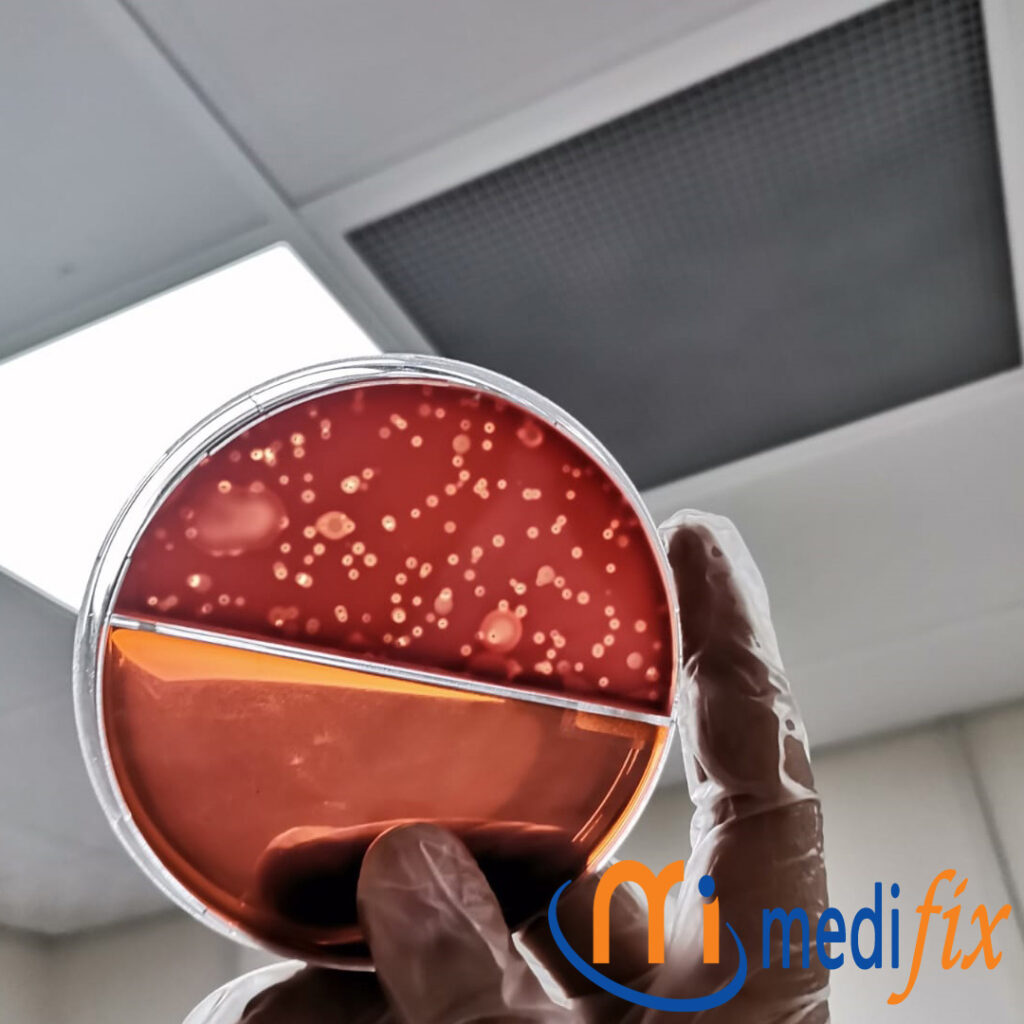
Hazır Besiyerleri

FİRMA MERKEZİ
Yüreğir/Adana
LABORATUVAR ÜRÜNLERİ
medios@medios.com.tr
DIŞ KALİTE KONTROL
info@turqas.com
Mikrobiyoloji
Anasayfa » Mikrobiyoloji